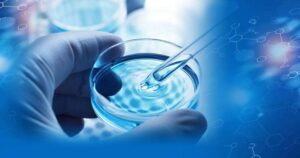

Soluções que transformam conhecimento em resultados eficientes para o seu negócio.
Soluções desenvolvidas com as metodologias mais recentes do mercado para otimizar seu produto.
Infraestrutura laboratorial de ponta da UTFPR e validação técnica de especialistas.
Foco em eficiência de recursos e gestão ambiental para processos mais limpos e econômicos.
Na Quanttum, a sustentabilidade não é um diferencial, é um compromisso!
Nossos projetos estão alinhados a 12 Objetivos de Desenvolvimento Sustentável (ODS) da ONU, integrando inovação, responsabilidade ambiental e impacto social em cada solução desenvolvida.
Quem somos
Referência em consultoria no setor químico, a Quanttum é a Empresa Júnior de Engenharia Química da UTFPR – Ponta Grossa.
Desde 2013, transformamos o conhecimento acadêmico em soluções de alto impacto, fundamentadas em inovação, sustentabilidade e tecnologia. Nosso diferencial reside na tríade de nossa excelência: o suporte técnico de professores especialistas, o acesso à infraestrutura de ponta da Universidade e a troca constante de experiências com a rede nacional de Empresas Juniores. Ao escolher a Quanttum, seu projeto é desenvolvido com as metodologias mais atuais do mercado, garantindo resultados de precisão e qualidade técnica superior. bibliográfico profundo até a fase de testes laboratoriais rigorosos. Transformamos o seu objetivo em um produto novo, tangível e validado, garantindo que a solução desenvolvida seja funcional, segura e pronta para enfrentar os desafios de um mercado competitivo.
Alto índice de satisfação comprovando a qualidade e o comprometimento dos nossos serviços.
Nossas cartas de serviço
Nosso foco é transformar desafios técnicos em soluções eficientes, seguras e economicamente viáveis!
Atuamos com consultoria em engenharia química, oferecendo suporte técnico especializado para indústrias, startups, laboratórios e organizações que necessitam de desenvolvimento de produtos, análises laboratoriais, gestão de processos e melhoria contínua da qualidade.
Oferecemos soluções para desafios técnicos, estratégicos e administrativos, atuando de forma próxima e contínua junto ao cliente, com um suporte que vai além de contratos pontuais. O serviço é flexível e adaptado às necessidades da empresa, podendo envolver diagnósticos internos, análises de processos, formação de comissões técnicas e apoio à tomada de decisão, sempre com embasamento técnico e acompanhamento profissional.
Otimizar e/ou padronizar operações de uma empresa de forma a reduzir custos ou riscos, utilizando de nosso conhecimento técnico para solucionar gargalos, tirar desperdícios, revisar procedimentos e atualizá-los. Consiste em uma carta ampla que pode tomar várias frentes mediante a necessidade do cliente.
Medir e quantificar parâmetros específicos de uma amostra, usando aparelhos e equipamentos disponíveis nos laboratórios da UTFPR, com auxílio de professores responsáveis e com expertise no tema da análise.
Processo estruturado voltado à transformação de ideias em produtos inovadores, tangíveis e competitivos no mercado. A atuação contempla duas frentes principais: o desenvolvimento de novos produtos e o aprimoramento de soluções já existentes. Todo o processo é sustentado por um pilar essencial de estudo técnico, que garante embasamento científico, viabilidade técnica e alinhamento com os objetivos do cliente.
Nossos
Cases
Confira alguns projetos e trabalhos de sucesso desenvolvidos pela Quanttum

Limpa-Tênis – Transformando a necessidade em inovação
O produto Assim como outros produtos de higienização, um limpa-tênis possui uma formulação que exige diversos ajustes técnicos para garantir a performance, segurança e responsabilidade ambiental do produto, unindo a
Blog
Confira nossos Artigos
Aqui você encontra conteúdos práticos sobre processos, qualidade, sustentabilidade e inovação, mostrando como a engenharia pode gerar eficiência, reduzir custos e atender às reais necessidades das empresas.
O que torna a Quanttum uma empresa confiável em engenharia química?
Em algum momento você já se perguntou se uma empresa administrada por estudantes pode oferecer soluções de confiança? Desde 2013, nós da Quanttum, Empresa Júnior da UTFPR, mostramos que o
A importância da colaboratividade
Qual a importância da colaboratividade em rede para a entrega de um projeto de impacto? A colaboratividade em rede é de extrema importância para que nossa empresa continue executando os
Controle Total: Sua Água no Padrão da Conformidade
A água é essencial para diversos processos e sua qualidade é um recurso fundamental. Para condomínios, indústrias ou qualquer outro empreendimento que utilize reservatórios internos, a análise periódica da água
Controle de Qualidade em Análises Laboratoriais
O controle de qualidade em análises químicas é fundamental para garantir que os resultados obtidos sejam confiáveis para a tomada de decisões. Em um laboratório, cada resultado influencia etapas posteriores
Controle de Qualidade em Análises Laboratoriais
O controle de qualidade em análises químicas é fundamental para garantir que os resultados obtidos sejam confiáveis para a tomada de decisões. Em um laboratório, cada resultado influencia etapas posteriores
Controle Total: Sua Água no Padrão da Conformidade
A água é essencial para diversos processos e sua qualidade é um recurso fundamental. Para condomínios, indústrias ou qualquer outro empreendimento que utilize reservatórios internos, a análise periódica da água
Preencha o formulário e entraremos em contato com você o mais breve possível.
Quem já confiou em nossas soluções?

















